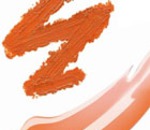

Последние новости из мира красоты
|
Алиса в Стране чудес – новый весенний тренд
03.03.2010
4 марта – мировая премьера, на экраны выйдет фильм Disney «Алиса в Стране чудес». И уже можно сказать, что фильму уготован успех – судите сами: столько сопутствующих товаров, на создание которых вдохновила картина, было, пожалуй, только у «Матрицы».
Читать далее »
пока нет комментариев
|
|
Летние вибрации от Givenchy
03.03.2010
Givenchy уже в марте нам дарит настроения и запахи лета, представляя лимитированные новинки - Very Irresistible Summer Vibrations и Play Summer Vibrations. Это женский и мужской запахи. Оба аромата имеют на флаконах принт в виде цветных окружностей, символизирующих яркое солнце и жаркие вечеринки – невероятные Summer Vibrations.
Читать далее »
|
|
Тильда Суинтон – киноактриса с необычной внешностью и аристократическими манерами, она редко играет обычных девушек и земных женщин. И хочется надеяться, что и аромат она выпустит не совсем привычный. Так ли это?
Читать далее »
|
|
Кейт Мосс станцует с Михаилом Барышниковым
02.03.2010
Супермодель Кейт Мосс снимется в кинофильме-балете. Это – возрождающийся сейчас жанр короткого кино. И главное, что для этой роли Кейт придется по-настоящему научиться танцевать, а её партнером будет не кто иной, как знаменитый русский танцовщик Михаил Барышников.
Читать далее »
|
|
Новая версия аромата Джона Гальяно
02.03.2010
Впервые аромат John Galliano был представлен в 2008 году, это была цветочно-альдегидная композиция с современными и специфическими нотами, основанными на свежести цитрусового чая, тепле летних цветов и древесных аккордов. Флакон аромата сразу привлек к себе внимание, особенно необычно смотрелся логотип Кутюрье на крышечке. А сейчас мы ожидаем новую редакцию этого шедевра.
Читать далее »
|
|
Оранжевый тренд
02.03.2010
Продукты морковного цвета – на пике своей популярности. Этот цвет присутствует во многих весенних и летних коллекциях. И если поначалу оранжевая подводка или апельсиновые губы кажутся вам чем-то «из ряда вон», то, посмотрев на продукты, которые предлагают мировые бренды, многие сомнения могут развеяться.
Читать далее »
|
|
Расскажите о самом смешном подарке в вашей жизни и выиграйте незабываемую бьюти-процедуру
02.03.2010
Женский портал красоты MyCharm.ru и Интернет-магазин vpodarok.ru подготовили для вас конкурс. Разыгрываются три подарка: «Spa luxe», «Spa» и «Красота» – это три бьюти-процедуры в одном из салонов Москвы или Санкт-Петербурга. Узнайте подробности о призах и о правилах нового конкурса.
Читать далее »
|
|
Кулинарный конкурс "Весна в сердце"
02.03.2010
Компания Scarlett совместно с Поварёнок.ру объявляют о проведении кулинарного конкурса для мужчин "Весна в сердце".
Читать далее »
|
|
NIVEA создал специальные продукты для ежедневного ухода за собой, предназначенные для подростков. Как известно, молодая кожа имеет свои проблемы, и немецкий бренд, создавая новые продукты, учитывал это. Встречайте продукты для юношей Menergy и для девушек Angel Star.
Читать далее »
|
|
Безусловно, такой эффект можно получить просто от использования геля для душа. Но можно ли сделать этот запах в виде духов, чтобы он держался 24 часа, каждые 7 дней в неделю? Парфюмерия CLEAN отвечает: возможно.
Читать далее »
|
|
Ну, вот и март! Наш портал красоты и NIVEA предлагают вам сказать Весне «здравствуй», а целлюлиту – «гуд-бай». В эту первую неделю марта мы проводим викторину, в которой можно выиграть один из пяти Антицеллюлитных гель-кремов «Гуд-бай, Целлюлит» от NIVEA. Сделайте себе такой подарок к 8 Марта! Читайте условия конкурса.
Читать далее »
|
|
Новый тренд маникюра: glossy + matte
01.03.2010
Как только появились матовые покрытия и лаки, у многих модниц зародилась идея их микшировать с глянцем. Это отличное решение как-то разнообразить свой ежедневный маникюр, если вы привыкли к одноцветным ногтям, но хочется хоть немного их оживить.
Читать далее »
|
|
Новинка от Shiseido, побеждающая время
28.02.2010
Встречайте: на рынок выходит Супервосстанавливающая сыворотка Super Corrective Serum от Shiseido. Этот продукт входит в гамму косметических средств Bio-Performance, которая создается при участии достижений биотехнологов. Авторы новинки утверждают, что теперь у вас есть неоспоримое преимущество в борьбе со временем.
Читать далее »
|
|
Коллекция для дизайна ногтей от Oriflame
28.02.2010
Шведский бренд косметики Oriflame делает подарок всем, кто любит экспериментировать с дизайном ногтей, творить и самовыражаться в маникюре. Для этого создана специальная коллекция для дизайна ногтей, в которую вошли три оттенка лака, а также набор блесток.
Читать далее »
|
|
Блеск для губ DIOR ADDICT ULTRA-GLOSS 2010
28.02.2010
Инновационный Центр Dior неустанно улучшает и обновляет Dior Addict Ultra-Gloss – блеск для губ, сочетающий в себе исключительные качества: эффектное сияние, объем и прекрасную палитру кутюрных оттенков со спецэффектами из несравненно легкой вуали. Новинка в продаже с 1 апреля 2010 года.
Читать далее »
|
|
Нужно ли защищать кожу от компьютера?
27.02.2010
Многие знают, что экраны телевизоров и мониторов излучают UV-лучи. Правда ли это, и как можно защитить себя от этого излучения? Ведь компьютер и телевизор занимают значительную часть нашей жизни. Так что по этому поводу говорят специалисты?
Читать далее »
|
|
Линия косметики от Topshop: свершилось!
27.02.2010
Эту премьеру ждали. О своих планах обзавестись собственной маркой декоративной косметики бренд Topshop заявлял ещё осенью прошлого года. И вот, наконец, мы можем посмотреть на новые продукты. Первыми новинки появятся в Великобритании в мае 2010-го, в 30 магазинах, и это будут две линии: основные (базовые) продукты и сезонные коллекции макияжа.
Читать далее »
|
|
Новый мужской аромат от Laura Biagiotti
27.02.2010
Misteri di Roma Uomo – парфюмерная новинка для мужчин, которая сочетает в себе красоту и очарование вечного города Рим и образ соблазнительного и чувственного мужчины, который увлекается красотой и не боится проявлять свои эмоции. Создатели аромата считают, что именно такие харизматичные мужчины могут ассоциироваться с Римом и его манящей аурой.
Читать далее »
|
|
Летний макияж для глаз от Chanel
27.02.2010
Если вы удивились, что в летней коллекции Chanel Les Pop-Up Summer 2010 не было привычных для этого бренда роскошных продуктов для глаз, то пришло время узнать, что Chanel готовит для этих целей отдельную коллекцию теней и новую тушь. Познакомьтесь с новыми палетками.
Читать далее »
|
|
Миллионы мужчин во всем мире ежедневно бреются перед началом рабочего дня. Каждый из них мечтает о таких средствах, которые сделают бритье комфортным, оставляющим лишь ощущение свежести, а не раздражения и сухость кожи.
Читать далее »
|
Страницы: